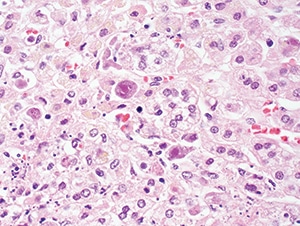
Figure 4.33. Cytomegalovirus adrenitis in a patient with AIDS, showing enlarged cells with intranuclear and cytoplasmic inclusions (H&E, 200X).

March 2018—New from CAP Press this month is the Atlas of Fundamental Infectious Diseases Histopathology: A Guide for Daily Practice, edited by Bobbi S. Pritt, MD, MSc, DTM&H. It covers bacterial, viral, fungal, and parasitic infections and contains more than 800 images. It’s intended to be “kept close by and referenced frequently,” says Dr. Pritt, professor of laboratory medicine and pathology, director of the clinical parasitology laboratory, and co-director of the vector-borne disease laboratory, Department of Laboratory Medicine and Pathology, Mayo Clinic, Rochester, Minn. Here is more of what Dr. Pritt told us about the new atlas. (See excerpt below.)
In what circumstances does the anatomic pathologist play a role in the diagnosis of infectious diseases, and what advantage does the anatomic pathologist have?
Anatomic pathologists play a huge role in the diagnosis of infectious diseases. They need to know the patterns of inflammation that are associated with infections, and they need to recognize when they are seeing a possible infectious organism under the microscope. In fact, even before they sit down at the scope, when they are dealing with the fresh specimen, they can greatly affect the care of a patient by identifying features that suggest the presence of an infectious entity and direct the collection of specimens for microbiology cultures.

Now if specimens are sent for cultures, you may ask why histopathologic examination is still important. The answer to this is threefold. First, even when specimens are sent for culture, the infectious organisms may fail to grow. This may be because the patient had been previously treated with antibiotics, the specimen sent for culture didn’t contain the organisms (i.e. sampling error), or the specimen wasn’t properly collected and transported to the laboratory. Also, not all organisms can grow in routine culture; the agents of syphilis, Whipple disease, and leprosy are such organisms. Second, cultures take time—sometimes weeks to months. This is well beyond the period in which clinical decisions must be made, and thus the initial diagnosis of infection may come from the anatomic pathologist. Third, anatomic pathologists have the advantage of visualizing the organism in the accompanying cellular and inflammatory milieu. By evaluating the host response (or lack thereof), they may determine whether an organism is invading or merely colonizing the tissue, or even just a contaminant on the slide.
What can you tell us about the content of the atlas and its organization?
The atlas starts with an introductory chapter containing many illustrative color pictures and tables on how to approach the diagnosis of infectious diseases. It then follows with specific chapters on bacteria, fungi, viruses, and parasites in anatomic pathology preparations. We use real examples of cases for each infectious disease and provide information for answering important questions that commonly arise in routine practice, such as: What is the typical inflammatory pattern associated with different microorganisms? What microorganism should I think of when seeing this morphology? What is the differential diagnosis? What additional studies are available to confirm my diagnosis? When should a differential diagnosis be conveyed to the clinical team caring for the patient? Our aim was to provide a practical guide for daily signout, and we therefore incorporated key diagnostic points, easy-to-reference tables, diagnostic algorithms, and numerous color photographs throughout all chapters of the atlas.
Do you cover infectious disease mimics in the atlas and, if so, how?
Yes, infectious disease mimics are a frequent cause of diagnostic confusion, and we have therefore included a special section on common infectious mimics at the end of each of the organism-specific chapters. For instance, we show photos of corpora amylacea, a common mimic of Cryptococcus and other yeasts, and incorporate several examples of how foreign objects (e.g. food material and hemostatic matrix) can be mistaken for different microorganisms. For each mimic, we discuss how it can be differentiated from true infectious organisms.
What can you tell us about the contributors and their backgrounds?
There are five of us, and we all love reviewing pathology related to infectious diseases. We come from a variety of settings and play a key role in diagnosing infectious diseases from anatomic pathology specimens at our institutions. We have rich clinical practices that routinely expose us to both common and rare infectious diseases and are excited to share our insight and experiences with the readers of our atlas. Each of us focused a large portion of our training on infectious diseases pathology.
What two or three things are most notable about this new atlas?
We set out to create a book that is kept close by and referenced frequently. Rather than an elaborate treatise on all aspects of microorganisms, it serves as a practical guide for routine anatomic pathology signout. To accomplish this, we employed a highly visual format with a lot of photos (over 800), diagnostic algorithms, and charts. All of these tools convey information in a succinct and readily accessible manner. We also placed a lot of emphasis on the differential diagnosis and the ancillary studies that help support the morphologic impression. And on a personal note, I am so grateful to have been given the chance to collaborate with such exemplary diagnosticians.
Other contributors to the atlas are Blaine A. Mathison, BS, M(ASCP); Dan A. Milner, MD, MSc; Gary W. Procop, MD, MS; and Audrey N. Schuetz, MD, MPH. To order the atlas (PUB127), call the CAP contact center at 800-323-4040 option 1. For members, $96; for others, $120 ($89 for ebook at ebooks.cap.org).
[hr]
Cytomegalovirus
Here’s a look inside the new Atlas of Fundamental Infectious Diseases Histopathology: A Guide for Daily Practice, from the chapter on viral infections.

General. Cytomegalovirus (human herpes virus-5 [HHV-5]) is an enveloped, icosahedral, double-stranded DNA virus in the Herpesviridae family. The virus is ubiquitous worldwide and can infect many cell types including epithelial and endothelial cells. Infection commonly occurs in early childhood and is usually acquired by exposure to virus-containing oral secretions and other body fluids. CMV may also be transmitted through infected blood products and transplanted organs. Women who acquire primary infection during pregnancy are at risk for transmitting CMV infection across the placenta to the fetus, during delivery, or by breast-feeding. As with all herpes viruses, CMV may establish a latent infection in the host and undergo subsequent reactivation.

Clinical manifestations. CMV may cause a broad spectrum of diseases in both immunocompetent and immunocompromised hosts, ranging from subclinical to fulminant, life-threatening infection. The initial infection is often asymptomatic but may be associated with a mononucleosis-like illness in children and young adults, including fatigue, lymphadenopathy, and hepatitis. Atypical lymphocytes such as those seen with primary EBV infection may be detected on peripheral blood smear. Immunocompromised patients are at risk for more serious disease including organ-specific involvement (eg, retinitis, pneumonia, myocarditis, gastrointestinal, and central nervous system [CNS] disease) and systemic manifestations. Patients at increased risk for severe disease include those with AIDS, solid organ transplant patients who are serologically negative for CMV and receive CMV-positive organs, and hematopoietic stem cell transplant recipients who are serologically positive and receive stem cells from CMV-negative donors. As many as one-third of transplant recipients may experience serious end-organ disease and are at risk for rejection of the transplanted organ. Retinitis is the most common manifestation in HIV-positive patients. Congenital and perinatal CMV infection may also result in retinitis, as well as developmental delays, intrauterine growth restriction, hepatosplenomegaly, and sensorineural hearing loss. CNS involvement is a serious concern and may result in seizures, hypotonia, microcephaly and periventricular necrosis.

(H&E, 1000X).
Pathologic features. Tissue samples are rarely taken in immunocompetent hosts with self-limited disease but may be performed for other reasons and will often demonstrate classic CMV viral cytopathic changes: cytomegaly (up to four times larger than uninfected cells), a large single basophilic to amphophilic Cowdry type A intranuclear inclusion (“owl’s eye”), and multiple dense, eosinophilic to basophilic cytoplasmic inclusions (Figs. 4.30 and 4.31). Cytoplasmic inclusions (but not nuclear inclusions) may be weakly positive with Gomori methenamine silver (GMS) and periodic acid-Schiff (PAS). In immunocompromised patients, the viral cytopathic effect is similar but may be more frequent and associated with necrosis and inflammatory infiltrates (Fig. 4.33). The type of cells with viral cytopathic change varies with the affected organ; in the gastrointestinal tract, kidney, and lung, CMV may involve both epithelial and endothelial cells. Alveolar macrophages in the lung may also be infected. Pneumonitis can result in nonspecific diffuse alveolar damage without necrosis for which careful examination is needed to find cells with characteristic viral cytopathic effect (Figs. 4.28 and 4.29). In the brain, neurons may contain characteristic inclusions. Retinitis in both congenital infection and HIV-related disease typically demonstrates retinal necrosis, vasculitis, and choroiditis. Immunohistochemical stains or ISH for CMV are helpful for demonstrating infected cells and may also highlight cells without obvious viral cytopathic effect (Fig. 4.32). Since incidental reactivation of CMV may be detected in immunocompromised patients with other infectious and noninfectious conditions, positive IHC or ISH staining must be carefully correlated with the clinical picture.

Differential diagnosis. CMV inclusions must be differentiated from other viral inclusions including those of HSV, VZV, adenovirus, BKV, and JCV. Use of virus-specific IHC or ISH stains and correlation with culture and PCR results are helpful for confirming the diagnosis. Other infectious and noninfectious entities such as graft-versus-host disease in hematopoietic stem cell transplant recipients can cause similar necrotic/inflammatory lesions and should be considered.

Ancillary tests. Qualitative PCR or culture can be performed on a variety of specimens and may be used to support the diagnosis of active infection. Quantitative CMV PCR is used primarily in immunocompromised individuals to assess risk of disease and monitor response to therapy. However, quantitative PCR results must be carefully interpreted since several studies have shown a clear disconnect between severe organ involvement and a lack of peripheral viremia and vice versa. Serologic assessment is useful for diagnosis of primary infection, especially in pregnant women and patients with a mononucleosis-like illness. It is also useful for risk stratification of transplant recipients and donors.
[hr]
Clark NM, Lynch JP 3rd, Sayah D, Belperio JA, Fishbein MC, Weigt SS. DNA viral infections complicating lung transplantation. Semin Respir Crit Care Med. 2013;34(3):380–404.
Fishman JA. Overview: cytomegalovirus and the herpesviruses in transplantation. Am J Transplant. 2013;13(Suppl 3):1–8.
Karre T. Herpes virus infections. In: Procop GW, Pritt BS, eds. Pathology of Infectious Diseases. Philadelphia, PA: Elsevier Saunders; 2015:17–36.
Kotton CN. CMV: prevention, diagnosis and therapy. Am J Transplant. 2013;13(Suppl 3):24–40.
Pillet S, Roblin X, Cornillon J, Mariat C, Pozzetto B. Quantification of cytomegalovirus viral load. Expert Rev Anti Infect Ther. 2014;12(2):193–210.
Razonable RR, Hayden RT. Clinical utility of viral load in management of cytomegalovirus infection after solid organ transplantation. Clin Microbiol Rev. 2013;26(4):703–727.
Söderberg-Nauclér C. Treatment of cytomegalovirus infections beyond acute disease to improve human health. Expert Rev Anti Infect Ther. 2014;12(2):211–222.
von Ranke FM, Zanetti G, Hochhegger B, Marchiori E. Infectious diseases causing diffuse alveolar hemorrhage in immunocompetent patients: a state-of-the-art review. Lung. 2013;191(1):9–18.
You DM, Johnson MD. Cytomegalovirus infection and the gastrointestinal tract. Curr Gastroenterol Rep. 2012;14(4):334–342.[hr]